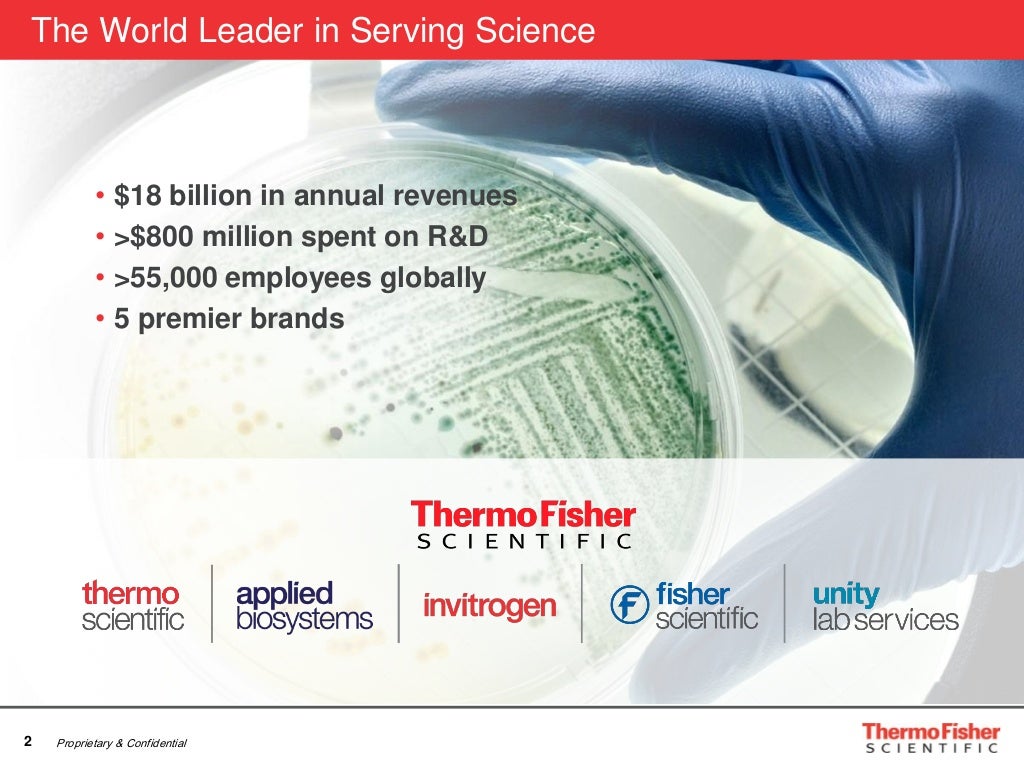

← thermo fisher scientific india pvt ltd mumbai Thermo fisher alert thermo fisher scientific india pvt ltd coa Thermo fisher krios g3i cryo-transmission electron microscope →
If you are searching about India Our Culture | Thermo Fisher Scientific you've came to the right place. We have 35 Pictures about India Our Culture | Thermo Fisher Scientific like India Our Culture | Thermo Fisher Scientific, India Our Culture | Thermo Fisher Scientific and also Thermo Fisher Scientific launches India Engineering Centre in Hyderabad. Here you go:
India Our Culture | Thermo Fisher Scientific

Thermo Fisher Scientific India Pvt Ltd

thermo fisher pvt
New Advanced Liquid Chromatography System Delivers Productivity

Thermo Fisher Scientific - Creating Revolution With Innovation

Thermo Fisher Invests $160 M To Expand Bioproduction Capacity In

Stratégia Disco Kivonat Thermo Scientific India Erőfeszítéseket Tesznek

Lab Equipments By Thermo Fisher Scientific India Pvt. Ltd, Mumbai

Lab Equipments By Thermo Fisher Scientific India Pvt. Ltd, Mumbai

thermo equipments pvt fisher mumbai lab
Thermo Fisher Scientific Announces Its First Cloud-Enabled Biological

cabinet thermo scientific safety biological cabinets biosafety fisher enabled cloud thermofisher height adjustable stand floor announces its first bsc a2
Thermo Fisher Scientific India Pvt Ltd - Manufacturer From Powai

Thermo Fisher Scientific India Pvt Ltd, Jayanagar 3rd Block - Toy

Thermo Fisher Scientific Launches India Engineering Centre In Hyderabad

Job Alert: Lead - Digital Marketing At Thermo Fisher Scientific ,India

thermo fisher alert
Resmi Vipin - Associate Manager - Thermo Fisher Scientific | LinkedIn
Thermo Fisher Sorvall ST 8 Small Benchtop Centrifuge Machine At Best

Stratégia Disco Kivonat Thermo Scientific India Erőfeszítéseket Tesznek

Thermo Fisher Krios G3i Cryo-Transmission Electron Microscope - Thermo

g3i thermo krios electron cryo
Thermo Fisher Scientific Hiring | Across India – Remote – Jobs4fresher.com

Thermo Fisher Scientific India On LinkedIn: #healthier #cleaner #safer
Lab Equipments By Thermo Fisher Scientific India Pvt. Ltd, Mumbai

pvt thermo equipments
Benchtop Meter Manufacturer In Mumbai Maharashtra India By Thermo

meter benchtop orion thermo versa scientific medidor mv sobremesa soporte medidores ise bordmodel vstar equipar vwr
Thermo Fisher (Total Nitrogen And Sulfur Analyzer) At Best Price In

Thermo Fisher Scientific Introduces ‘On The Go’ Mobile App In India

Thermo Fisher Scientific Launches India Engineering Centre In Hyderabad

Thermo Fisher Scientific India On LinkedIn: Thermo Fisher Scientific
Lab Equipments By Thermo Fisher Scientific India Pvt. Ltd, Mumbai
equipments thermo
Thermo Fisher Scientific (India) Pvt. Ltd., Mumbai, Heating Equipment

Thermo Fisher Scientific India Pvt Ltd, Jayanagar 3rd Block - Toy

Thermo Fisher Scientific India Pvt Ltd, Satpur - Scientific Instrument

India Our Culture | Thermo Fisher Scientific

Thermo Fisher Scientific India Pvt. Ltd.

Lab Equipments By Thermo Fisher Scientific India Pvt. Ltd, Mumbai

mumbai fisher thermo pvt equipments
Lab Equipments By Thermo Fisher Scientific India Pvt. Ltd, Mumbai

fisher thermo equipments pvt scientific
Verseny Visszavonulás Egyetemi Tanár Thermo Fisher Scientific Address

Thermo Fisher Scientific Launches India Engineering Centre In Hyderabad

Thermo fisher scientific india pvt ltd. Meter benchtop orion thermo versa scientific medidor mv sobremesa soporte medidores ise bordmodel vstar equipar vwr. Thermo fisher scientific india pvt ltd, jayanagar 3rd block